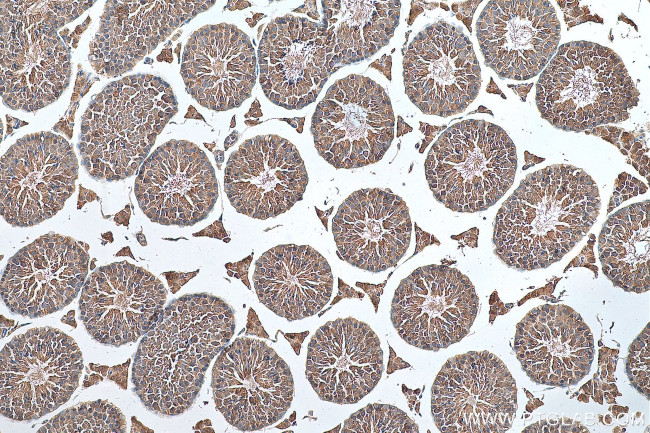
RNF17 Antibody in Immunohistochemistry (Paraffin) (IHC (P))
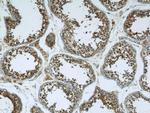
RNF17 Antibody in Immunohistochemistry (Paraffin) (IHC (P))

Search
Proteintech
RNF17 Polyclonal Antibody
{{$productOrderCtrl.translations['antibody.pdp.commerceCard.promotion.promotions']}}
{{$productOrderCtrl.translations['antibody.pdp.commerceCard.promotion.viewpromo']}}
{{$productOrderCtrl.translations['antibody.pdp.commerceCard.promotion.promocode']}}: {{promo.promoCode}} {{promo.promoTitle}} {{promo.promoDescription}}. {{$productOrderCtrl.translations['antibody.pdp.commerceCard.promotion.learnmore']}}
产品信息
24302-1-AP
种属反应
宿主/亚型
分类
类型
抗原
偶联物
形式
浓度
规格
纯化类型
保存液
内含物
保存条件
运输条件
产品详细信息
Immunogen sequence: ICMFNNMGK IEFRDSTKCY PQENEIRQNV QKKYNNKKEL SCYDTYPPLE KKKVDMSVLT SEAPPPPLQP ETNDVHLEAK NFQPQKDVAT ASPKTIAVLP QMGSSPDVII EEIIEDNVES SAELVFVSHV IDPCHFYIRK YSQIKDAKVL EKKVNEFCNR SSHLDPSDIL ELGARIFVSS IKNGMWCRGT ITELIPIEGR NTRKPCSPTR LFVHEVALIQ IFMVDFGNSE VLIVTGVVDT HVRPEHSAKQ HIALNDLCLV LRKSEPYTEG LLKDIQPLAQ PCSLKDIVPQ NSNEGWEEEA KVEFLKMVNN KAVSMKVFRE EDGVLIVDLQ KPPPNKISSD MPVSLRDALV FMELAKRT (296-652 aa encoded by BC146822)
靶标信息
RNF17 also termed as ring finger protein 17 is a 1623 amino acid protein, which contains 1 ring type zinc finger and 4 tudor domains. RNF17 is specifically expressed in testis. The RING finger motif presents in many ubiquitin E3 ligases. RNF17 interacts with all four members of the Mad family (Mad1, Mxi1, Mad3 and Mad4), which are basic-helix-loop-helix-leucine zipper transcription factors of the Myc oncoprotein network. RNF17 is component of the tectonic-like complex, which is required for ciliogenesis and sonic hedgehog/SHH signaling. RNF17 is able to form dimers or polymers both in vitro and in vivo, indicating that it may play a role in the assembly of RNF17 granules. RNF17 encodes a novel key regulator of spermiogenesis.
仅用于科研。不用于诊断过程。未经明确授权不得转售。
篇参考文献 (0)
生物信息学
蛋白别名: Mad member-interacting protein 2; Max dimerization protein member-interacting protein 2; Mmip-2; RING finger protein 17; spermatogenesis associated 23; tudor domain containing 4; Tudor domain-containing protein 4; unnamed protein product
基因别名: MMIP-2; Mmip2; RNF17; SPATA23; TDRD4
UniProt ID: (Human) Q9BXT8, (Mouse) Q99MV7
Entrez Gene ID: (Human) 56163, (Mouse) 30054